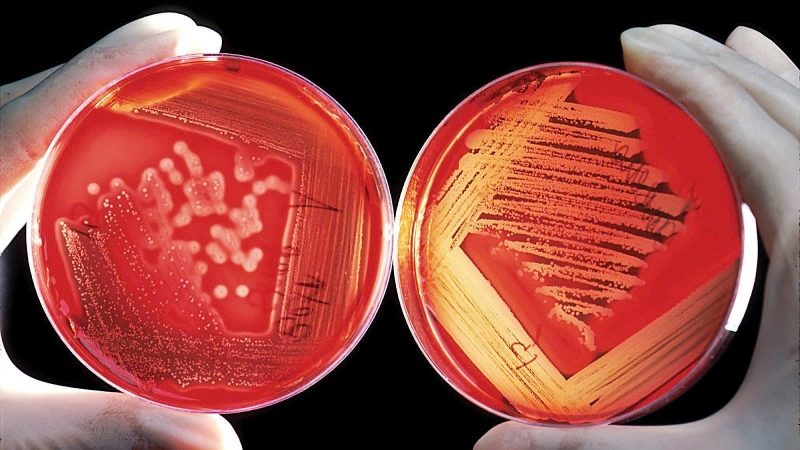
Chẩn đoán nhiễm khuẩn huyết theo Bộ Y tế 3

Tốt nghiệp loại giỏi trường Đại học Y Dược Huế. Từng tham gia nghiên cứu khoa học đề tài về Dược liệu. Nhiều năm kinh nghiệm làm việc trong lĩnh vực Dược phẩm. Hiện đang là giảng viên cho Dược sĩ tại Nhà thuốc Long Châu.
Anh Đức
30/12/2024
Mặc định
Lớn hơn
Nhiễm khuẩn huyết là một tình trạng nhiễm trùng nghiêm trọng. Chẩn đoán nhiễm khuẩn huyết Bộ Y tế yêu cầu sự kết hợp giữa các triệu chứng lâm sàng và xét nghiệm cận lâm sàng để xác định mức độ nghiêm trọng của bệnh.
Nhiễm khuẩn huyết là một trong những nguyên nhân gây tử vong hàng đầu trên thế giới, chiếm khoảng 20% tổng số ca tử vong toàn cầu theo báo cáo của Tổ chức Y tế Thế giới (WHO). Việc chẩn đoán chính xác và kịp thời có vai trò quan trọng trong quá trình điều trị và giảm thiểu nguy cơ tử vong. Dưới đây là những thông tin cần thiết để hiểu rõ hơn về nhiễm khuẩn huyết và các phương pháp chẩn đoán nhiễm khuẩn huyết Bộ Y tế.
Nhiễm khuẩn huyết là tình trạng cơ thể phản ứng bất thường với nhiễm trùng, dẫn đến rối loạn chức năng hoặc suy các cơ quan. Đây là một tình trạng y tế nguy hiểm, có khả năng đe dọa đến tính mạng nếu không được can thiệp kịp thời.
Các tiêu chí đánh giá rối loạn chức năng cơ quan:
Ở trẻ em, các chỉ số như nhiệt độ, nhịp tim, nhịp thở, độ bão hòa oxy và thời gian đổ đầy mao mạch cần được theo dõi sát sao.

Nhiễm khuẩn huyết thường biểu hiện qua các dấu hiệu đặc trưng, bao gồm:
Ngoài ra, các chất trung gian như cytokine, protease, chất trung gian lipid và peptide hoạt mạch cũng góp phần quan trọng trong tiến trình bệnh lý.
Nhiễm khuẩn huyết có thể xảy ra ở bất kỳ ai sau khi trải qua chấn thương hoặc nhiễm trùng nhỏ. Tuy nhiên, các nhóm đối tượng sau đây có nguy cơ cao hơn:

Chẩn đoán nhiễm khuẩn huyết kịp thời và chính xác đóng vai trò quan trọng trong việc xác định mức độ nghiêm trọng của bệnh và hướng dẫn điều trị. Dưới đây là các phương pháp chẩn đoán nhiễm khuẩn huyết Bộ y tế đưa ra.
Xét nghiệm trong phòng thí nghiệm là phương pháp quan trọng để xác định các dấu hiệu của nhiễm khuẩn huyết. Các xét nghiệm này có thể bao gồm kiểm tra máu, nước tiểu và cấy vi khuẩn để phát hiện nguồn gốc nhiễm trùng và mức độ nghiêm trọng của bệnh.
Xét nghiệm số lượng tế bào máu (CBC) giúp phát hiện các bất thường trong số lượng bạch cầu, tiểu cầu và hồng cầu.
Chỉ số bất thường:
Đây là phương pháp chính xác để xác định vi khuẩn hoặc vi sinh vật gây bệnh.
Thực hiện cấy máu, cấy dịch từ đường truyền tĩnh mạch (IV) hoặc cấy từ các mẫu dịch cơ thể khác như dịch não tủy, dịch phổi hoặc dịch ổ bụng.
Kết quả: Việc xác định được vi khuẩn gây bệnh sẽ giúp lựa chọn đúng loại kháng sinh điều trị.
Được thực hiện để phát hiện nhiễm trùng đường tiết niệu, đặc biệt ở bệnh nhân có ống thông tiểu hoặc có các yếu tố nguy cơ khác.
Thực hiện: Nhuộm Gram, phân tích nước tiểu và cấy nước tiểu để phát hiện vi khuẩn.
Kết quả: Nhiễm trùng đường tiết niệu có thể là nguồn lây lan dẫn đến nhiễm khuẩn huyết.
Dưới đây là các chỉ số quan trọng cần theo dõi trong chẩn đoán nhiễm khuẩn huyết Bộ Y tế:

Các kỹ thuật chẩn đoán hình ảnh giúp phát hiện vị trí nhiễm trùng ban đầu và các biến chứng.
Chụp X-quang giúp xác định vị trí nhiễm trùng phổi, viêm phổi hoặc các biến chứng như thâm nhiễm phổi. Các hình ảnh thâm nhiễm hoặc đốm trắng trên phổi có thể cho thấy dấu hiệu nhiễm trùng.
Một số phương pháp xâm lấn có thể được thực hiện để chẩn đoán nguyên nhân nhiễm khuẩn huyết. Chọc dò lồng ngực hoặc ổ bụng để lấy mẫu dịch làm xét nghiệm. Ví dụ chọc dò màng phổi để xác định nguyên nhân tràn dịch màng phổi. Chọc dò dịch ổ bụng để phát hiện vi khuẩn trong dịch cổ trướng.
Phương pháp chẩn đoán nhiễm khuẩn huyết rất đa dạng, bao gồm các xét nghiệm máu, cấy vi khuẩn, chụp X-quang, CT, MRI và các can thiệp xâm lấn. Việc phát hiện sớm và chẩn đoán chính xác có vai trò quan trọng trong việc giảm thiểu tỷ lệ tử vong. Để xác định được nguồn nhiễm trùng, bác sĩ cần thực hiện đầy đủ các phương pháp trên, từ xét nghiệm máu đến kiểm tra hình ảnh và can thiệp xâm lấn.
Việc chẩn đoán nhiễm khuẩn huyết chính xác và kịp thời giúp cải thiện đáng kể tỷ lệ sống sót của bệnh nhân. Các bác sĩ cần phối hợp chặt chẽ trong việc sử dụng các công cụ chẩn đoán hiện đại như xét nghiệm procalcitonin, CT/MRI và các xét nghiệm máu chuyên sâu để xác định nguyên nhân.
Chẩn đoán nhiễm khuẩn huyết không chỉ dựa trên các triệu chứng lâm sàng mà còn cần sự hỗ trợ từ các xét nghiệm và công cụ chẩn đoán hiện đại. Hiểu rõ các dấu hiệu và phương pháp chẩn đoán là bước quan trọng để giảm thiểu rủi ro tử vong do nhiễm khuẩn huyết. Điều này đặc biệt cần thiết đối với các nhóm đối tượng có nguy cơ cao như trẻ em, người cao tuổi và người có bệnh lý mãn tính.
Việc áp dụng các quy trình chẩn đoán nhiễm khuẩn huyết Bộ Y tế sẽ góp phần nâng cao hiệu quả điều trị và chất lượng chăm sóc y tế. Chẩn đoán kịp thời không chỉ cứu sống bệnh nhân mà còn giảm gánh nặng tài chính cho hệ thống y tế và gia đình.
Dược sĩ Đại họcNgô Kim Thúy
Tốt nghiệp loại giỏi trường Đại học Y Dược Huế. Từng tham gia nghiên cứu khoa học đề tài về Dược liệu. Nhiều năm kinh nghiệm làm việc trong lĩnh vực Dược phẩm. Hiện đang là giảng viên cho Dược sĩ tại Nhà thuốc Long Châu.